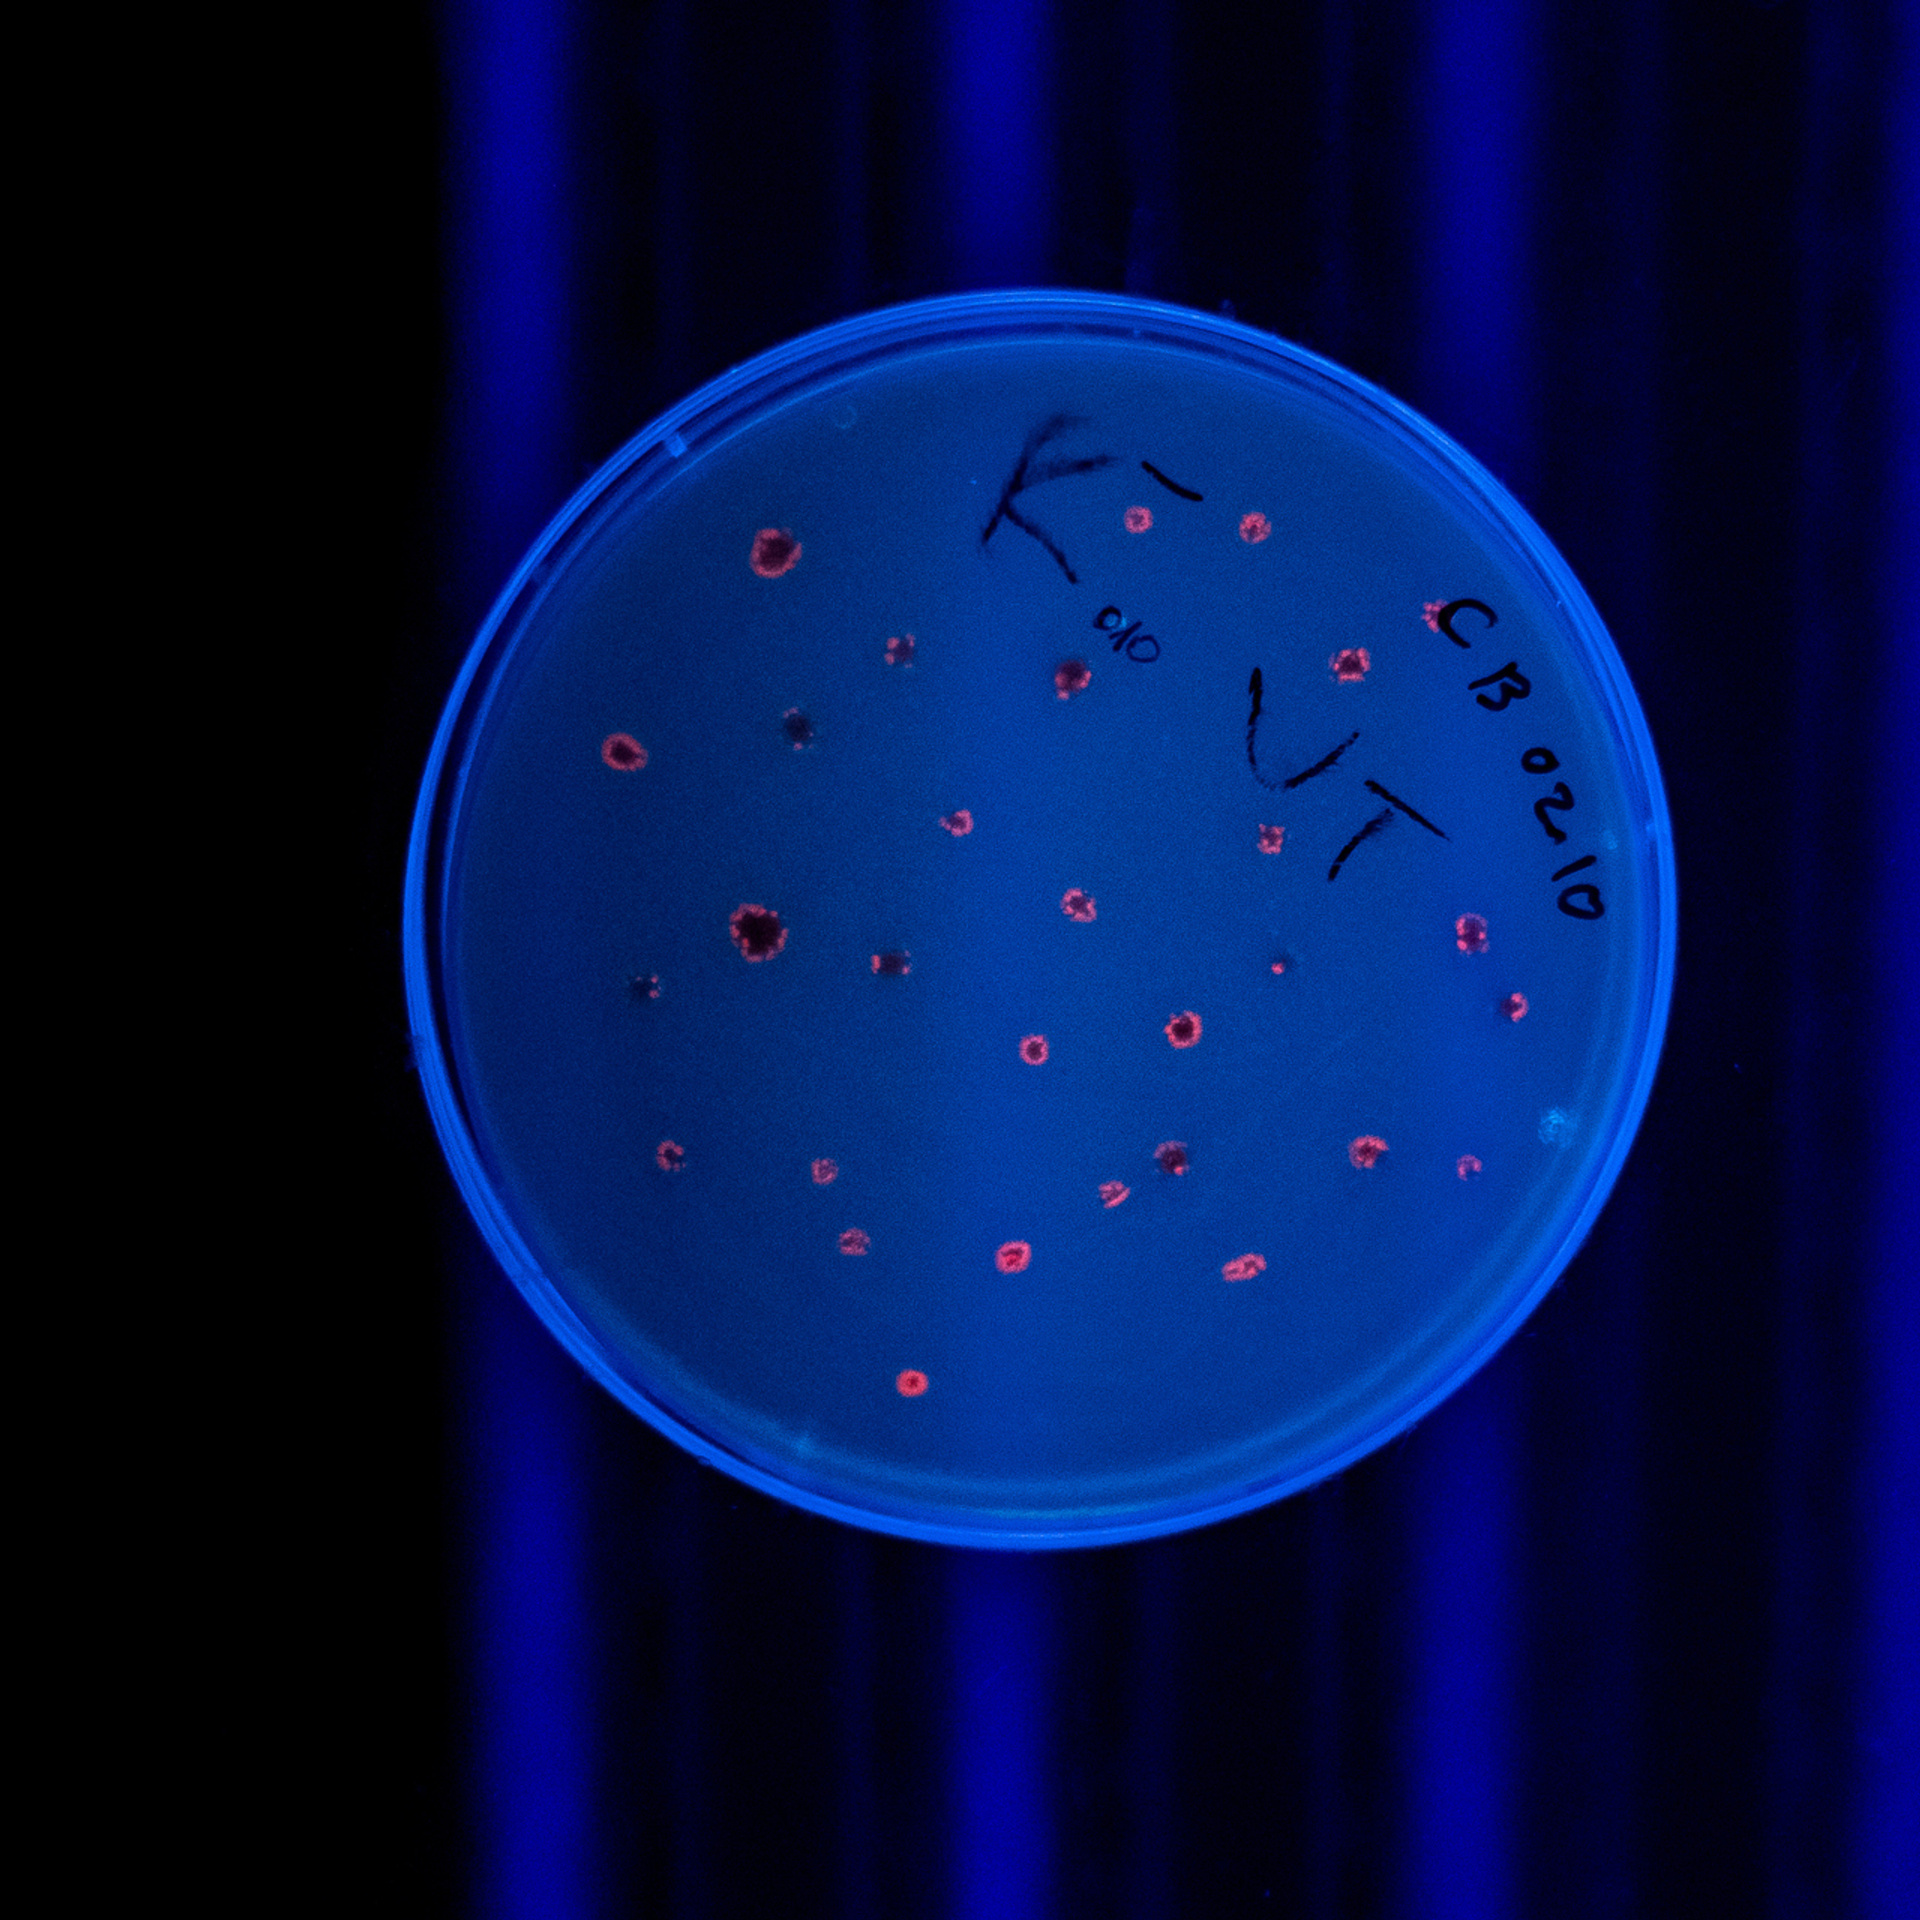
My students. Evgeny Pelevin. Photographer. Industry, reporting, weddings, portrait

Svetlana
Anastasia
Ivan
Anna
“Evgeny taught not to be afraid expensive equipment, turn the settings with supersonic speed, optimize effort, work in a team and enjoy from each photo. And he’s just awesome. Thank you, Evgeny! “
Vladislav
“Even in my early childhood, I wanted to reduce my life to photography and cinema. I decided to start with photography, but, of course, this was not taught at school, so I looked for courses in photography. And my choice fell on “Unium” at the Moscow Institute of Physics and Technology, where Evgeny Pelevin became my teacher.
It was around 2014. When I arrived, I had my parents' cheap, easy-to-handle portable camera on my hands. And from all my knowledge of photography, there was only the Auto mode on the camera. At first, I felt ‘out of my element’ because other guys at that time had at least some kind of SLR cameras. For about a month, I took pictures with just the same cheap camera, trying to squeeze at least something out of it. Evgeny showed that even my camera has a ‘Manual’ mode and I learned from it and tried to work.
After a while I bought a Canon 650D SLR camera, for me it was ‘heaven and earth’ compared to what I have it was early. Then I got a great motivation to take pictures and create. During the year of study, Evgeny taught me something that I didn’t know at all and couldn’t even imagine: all the concepts of photography, all the basics of different genres of photography, chips for which no costs are required (which I use to this day). And in one year, my level of photography has grown quite a lot.
Evgeny himself is a very kind person, with whom you definitely won’t be bored in class. It is impossible to get bored or sleep in his lessons. You always learn something new for yourself. He is also a person to whom you can always turn for help and, despite his busyness, he will always answer.
Usually, after training, students do not intersect with their teachers. But this is not my story, Evgeny and I remained friends. After 3 years, he helped me with pre-graduation practice, when I was already studying to be a photographer at the VGIK branch. And this month of practice flew by for me unnoticed. He threw me the most interesting shots, from which I pulled out the most juicy shots. Some of these shootings were: a press conference of D. A. Medvedev, the MIPT festival ‘Fest Tech’, where I filmed the ‘Khleb’ group and others in a photo pit. And the most amazing thing is that in a year of studying with Evgeny at Unium, I learned more than in 3 years of studying as a photographer in the branch.
I am very glad that life brought me together with this man.”
Kirill
“I received inspiration from the courses, good humor, a coherent presentation of material, gingerbread and whips, and acquaintance with worthy people. Oh, yes!, after all this, I began to receive money for the photo from time to time, the level of photos of some makes me a little jealous. By the way, various kinds of knowledge that Evgeny gives over the course, in the meantime, made it possible to start filming a video .”
Timofey
Nataly
”They say a lot depends on the teacher. I believe it’s true! If the teacher instills desire and zeal in you, then you will enjoy learning. So it was with Zhenya in the courses. Every lesson my mouth opened and closed after I went home! I was just delighted with how interesting and easy it is to invest knowledge! I still love photography and I try, if possible, to take my clients and set up photo shoots. I recommend courses from Evgeny Pelevin! And I wish you to also fall in love with photography, like him, also adore your job!”
Nikita
“Your courses have given me the necessary technical tools to further connect my life with photography. And the best thing is that you never shy away from additional questions and the fact that they get to the bottom of you. You always go the extra mile, which gives those who really want to grow and develop photography, this is a great opportunity.“